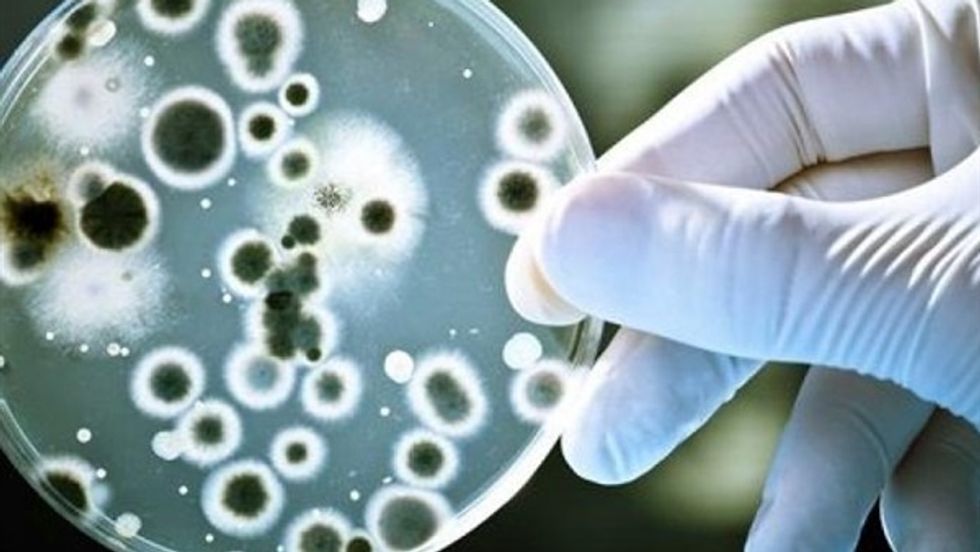

Ever wonder how many teaspoons it might take to fill the Atlantic Ocean? No? Well, then maybe you'll find the other 9 interesting.
1. There is enough DNA in an average person's body to stretch from the sun to Pluto and back 17 times

The human genome, the genetic code in each human cell, contains 23 DNA molecules each containing from 500 thousand to 2.5 million nucleotide pairs. DNA molecules of this size are 1.7 to 8.5 cm long when uncoiled, or about 5 cm on average. There are about 37 trillion cells in the human body and if you'd uncoil all of the DNA encased in each cell and put them end to end, then these would sum to a total length of 2×10 meters or enough for 17 Pluto roundtrips (1.2×10 meters/Pluto roundtrip.)
2. The average human body carries 10 times more bacterial cells than human cells
It's funny how we compulsively wash our hands, spray our countertops and grimace when someone sneezes near us—in fact, we do everything we can to avoid unnecessary encounters with the germ world. The truth of the matter is that each and every one of us is a walking petri dish! All the bacteria living inside you would fill a half-gallon jug or 10 times more bacterial cells in your body than human cells, according to Carolyn Bohach, a microbiologist at the University of Idaho. Don't worry, though. Most of these bacteria are helpful; in fact, we couldn't survive without them.
For one thing, bacteria produce chemicals that help us harness energy and nutrients from our food. Germ-free rodents have to consume nearly a third more calories than normal rodents to maintain their body weight, and when the same animals were later given a dose of bacteria, their body fat levels spiked, even if they didn't eat any more than they had before. The gut bacteria are also very important to maintaining immunity.
3. It can take a photon 40,000 years to travel from the core of the sun to its surface, but only eight minutes to travel the rest of the way to Earth

Photon travels, on average, a particular distance before being briefly absorbed and released by an atom, which scatters it in a new random direction. From the core to the sun's surface (696,000 kilometers) where it can escape into space, a photon needs to make a huge number of drunken jumps. The calculation is a little tricky, but the conclusion is that a photon takes between many thousands and many millions of years to drunkenly wander to the surface of the sun. In a way, the light that reaches us today is energy produced maybe millions of years ago. Amazing!
4. At over 2000 kilometers long, the Great Barrier Reef is the largest living structure on Earth

Coral reefs consist of huge numbers of individual coral polyps—soft-bodied, invertebrate animals—linked by tissue. The Great Barrier Reef is an interlinked system of about 3000 reefs and 900 coral islands, divided by narrow passages, just beneath the surface of the Coral Sea. Spanning more than 2000 km and covering an area of some 350,000 sq km, it is the largest living structure on Earth and the only one visible from space. But this fragile coral colony is beginning to crumble, battered by the effects of climate change, pollution, and manmade disasters.
5. There are eight times as many atoms in a teaspoon of water as there are teaspoons of water in the Atlantic Ocean

A teaspoon of water (about 5 mL) contains 2×10 water molecules, but each water molecule is comprised of three atoms: two hydrogens and one oxygen. Moreover, if you'd laid down end to end each water molecule from a teaspoon, you'd end up with a length of 50 billion km, or 10 times the width of our solar system.
6. The average person walks the equivalent of five times around the world in a lifetime

The average moderately active person takes around 7,500 steps a day. If you maintain that daily average and live until 80 years of age, you'll have walked about 216,262,500 steps in your lifetime. Doing the math, the average person with the average stride genome that lives until 80 will walk a distance of around 110,000 miles. This is the equivalent of walking about 5 times around the Earth, right on the equator.
7. When Helium is cooled to almost absolute zero (-460°F or -273°C), the lowest temperature possible, it becomes a liquid with surprising properties: it flows against gravity and will start running up and over the lip of a glass container

We all know helium as a gas for blowing up balloons and making people talk like chipmunks, but what most people don't know is that it comes in two distinct liquid states, one of which is borderline creepy. When helium is just a few degrees below its boiling point of -452 degrees Fahrenheit (-269 degrees Celsius) it will suddenly be able to do things that other fluids can't, like dribble through molecule-thin cracks, climb up and over the sides of a dish, and remain motionless when its container is spun. No longer a mere liquid, the helium has become a superfluid—a liquid that flows without friction.
"If you set [down] a cup with a liquid circulating around and you come back 10 minutes later, of course, it's stopped moving," says John Beamish, an experimental physicist at the University of Alberta in Edmonton. Atoms in the liquid will collide with one another and slow down. "But if you did that with helium at low temperature and came back a million years later," he says, "it would still be moving."
8. If Betelgeuse would explode, transiting from the red supergiant stage to supernova, then our sky would light continuously for two months. It can happen anytime, within a couple of thousand years, tomorrow or even now

Betelgeuse lies some 430 light-years from Earth. Yet it's already one of the brightest stars in Earth's sky. The reason is that Betelgeuse is a supergiant star. Betelgeuse has a luminosity about 10,000 times that of the sun and its radius is calculated to be about 370 times that of the sun. If it were positioned at the center of our sun, its radius would extend out past the orbit of Mars. Because it's near the end of its lifetime, Betelgeuse is likely to explode into a supernova.
9. An individual blood cell takes about 60 seconds to make a complete circuit of the body

The average heart pumps about 70 mL of blood out with each beat. Also, a healthy heart beats around 70 times a minute. So, if you multiply the amount of blood that the heart can pump by the number of beats in a minute, you actually get about 4.9 liters of blood, which is almost your whole body's worth of blood. In just a minute, the hearts pumps the entire blood volume around your body.
10. You are not alone

The known universe is made up of 50,000,000,000 galaxies. There are between 100,000,000,000 and 1,000,000,000,000 stars in a normal galaxy. In the Milky Way alone, there might be as many as 100 billion Earth-like planets. And no one knows who live in those galaxies. Still, you think you're alone.



















